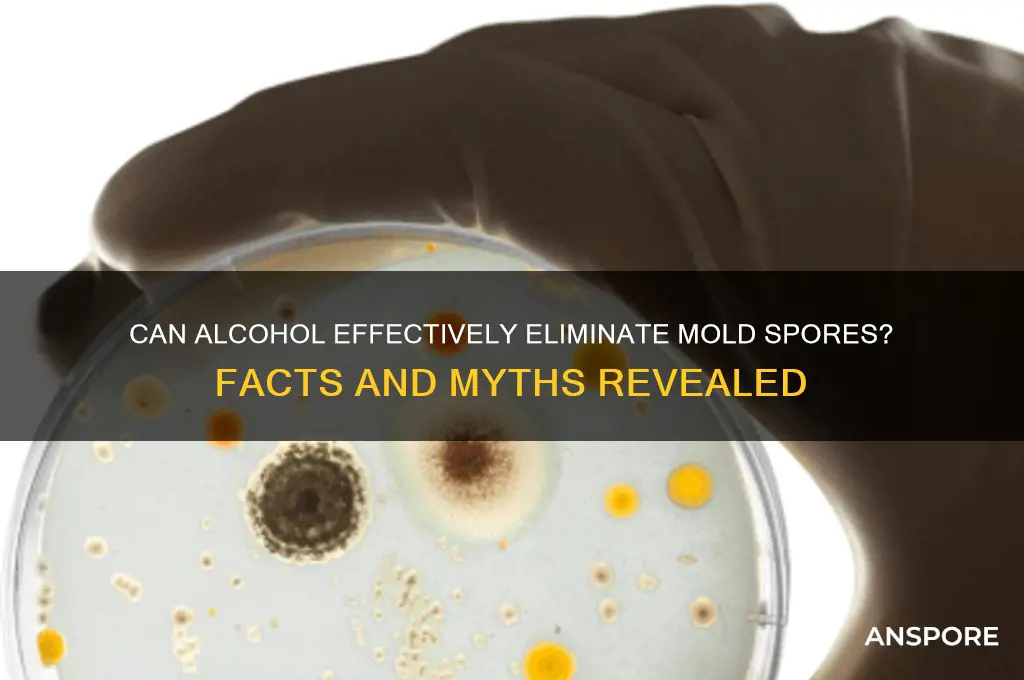
will alcohol kill mold spores

The question of whether alcohol can effectively kill mold spores is a common concern for those dealing with mold issues. Alcohol, particularly isopropyl alcohol, is often touted as a household disinfectant, but its efficacy against mold spores is nuanced. While alcohol can kill certain types of mold on non-porous surfaces by disrupting their cell membranes, it may not penetrate porous materials deeply enough to eliminate spores entirely. Additionally, alcohol evaporates quickly, which can limit its contact time with mold. For thorough mold remediation, especially in cases of extensive growth, professional methods and specialized products are often recommended to ensure complete eradication.
| Characteristics | Values |
|---|---|
| Effectiveness on Mold Spores | Alcohol (e.g., isopropyl alcohol) can kill mold spores on surfaces. |
| Concentration Required | At least 70% isopropyl alcohol is recommended for effective mold removal. |
| Surface Application | Works best on non-porous surfaces like glass, metal, and plastic. |
| Porous Materials | Less effective on porous materials (e.g., wood, fabric) as spores may penetrate deeper. |
| Drying Time | Alcohol evaporates quickly, reducing moisture that mold needs to thrive. |
| Residual Protection | Does not provide long-term protection; mold may regrow if conditions are favorable. |
| Safety Precautions | Flammable; use in well-ventilated areas and avoid open flames. |
| Environmental Impact | Generally considered safe for household use but should be disposed of properly. |
| Alternative Solutions | Bleach, vinegar, or commercial mold removers may be more effective in some cases. |
| Prevention | Alcohol can help disinfect surfaces but does not address underlying moisture issues. |
Explore related products
$13.48 $14.13
What You'll Learn

Alcohol's effectiveness against mold spores
Consider the mechanism: alcohol works by denaturing proteins and dissolving cell membranes, which can disrupt mold spores. However, this process requires direct contact and sufficient dwell time—typically 10–15 minutes. Spraying or wiping alcohol onto moldy surfaces may appear to clean them, but residual spores often survive, especially in hidden crevices or within materials. For this reason, alcohol is best used as a supplementary cleaner rather than a primary mold remediation tool. Pairing it with mechanical removal (e.g., scrubbing) and proper ventilation enhances its effectiveness.
Comparatively, other agents like bleach or vinegar are often preferred for mold remediation. Bleach, a stronger disinfectant, can penetrate porous surfaces better than alcohol, though it may discolor or damage certain materials. Vinegar, while milder, has antifungal properties and is safer for prolonged use. Alcohol’s advantage lies in its safety profile—it’s less corrosive and evaporates quickly, reducing the risk of residue. However, its limited penetration and spore-killing ability make it a secondary choice for mold control, particularly in severe cases.
Practical application tips can maximize alcohol’s utility. For small mold patches on non-porous surfaces, apply 70% isopropyl alcohol directly, let it sit for 15 minutes, then scrub and wipe clean. Repeat as needed. Avoid using alcohol on electronics or delicate fabrics, as it can cause damage. For porous materials, combine alcohol with physical removal methods like sanding or scraping, followed by a more potent antifungal treatment. Always wear gloves and ensure proper ventilation when using alcohol to avoid skin irritation or inhalation risks.
In conclusion, while alcohol can kill mold spores under specific conditions, its effectiveness is limited by concentration, surface type, and application technique. It’s a useful tool for minor surface mold but falls short for deep or widespread infestations. For comprehensive mold remediation, combine alcohol with mechanical removal and stronger antifungal agents. Understanding its strengths and limitations ensures it’s used appropriately, preventing recurrence and ensuring a healthier environment.
Can Lysol Spray Effectively Eliminate Airborne Mold Spores in Your Home?
You may want to see also

Concentration needed to kill spores
Alcohol's effectiveness against mold spores hinges on its concentration. Isopropyl alcohol, commonly known as rubbing alcohol, is a go-to household disinfectant, but its mold-killing prowess depends on its strength. Diluted solutions, like the 70% isopropyl alcohol often found in stores, are effective against many bacteria and viruses but fall short when it comes to mold spores. These resilient structures require a higher concentration to be eradicated.
A minimum of 90% isopropyl alcohol is recommended for mold spore eradication. This higher concentration ensures the alcohol can penetrate the spore's protective coating and disrupt its cellular structure, leading to its demise.
The application method is crucial for success. Simply spraying a surface with high-concentration alcohol might not be enough. For best results, apply the 90% isopropyl alcohol directly to the moldy area using a cloth or sponge, ensuring thorough saturation. Allow the alcohol to dwell on the surface for at least 10 minutes to give it ample time to penetrate and destroy the spores. After treatment, wipe away any visible mold and residue with a clean, damp cloth.
Caution: Undiluted, high-concentration alcohol is flammable. Always use it in a well-ventilated area and avoid open flames or sparks during application.
While 90% isopropyl alcohol is effective, it's not the only option. Ethanol, another type of alcohol, can also be used at a concentration of 70% or higher. However, ethanol is less readily available in high concentrations for household use compared to isopropyl alcohol.
Remember, alcohol is a surface disinfectant. It won't address the underlying cause of mold growth, which is often moisture. To prevent mold recurrence, identify and fix the source of moisture, whether it's a leak, condensation, or high humidity. Combine alcohol treatment with proper ventilation and moisture control for a comprehensive mold management strategy.
Can Heat Kill Mold Spores? Effective Temperatures and Methods Explained
You may want to see also

Types of alcohol for mold removal
Alcohol's effectiveness against mold spores hinges on its concentration and type. Isopropyl alcohol, commonly known as rubbing alcohol, is a household staple often touted for its disinfecting properties. At concentrations of 70% or higher, it can indeed kill mold spores on non-porous surfaces like glass, metal, and countertops. However, its efficacy diminishes on porous materials like wood or fabric, where spores can penetrate deeper than the alcohol can reach. For best results, apply undiluted 91% isopropyl alcohol directly to the affected area, let it sit for 10–15 minutes, then scrub and wipe clean. Always ensure proper ventilation when using isopropyl alcohol, as its fumes can be irritating.
While isopropyl alcohol is widely available, ethanol (grain alcohol) is another viable option for mold removal, particularly in food-safe applications. Food-grade ethanol, typically found at concentrations of 70–95%, can be used to clean kitchen surfaces or areas where chemical residue is a concern. Its advantage lies in its safety profile—it’s less toxic and evaporates quickly, leaving minimal residue. To use, mix 70% ethanol with water in a 1:1 ratio for a milder solution, or apply undiluted for tougher mold spots. Note that ethanol is flammable, so store it away from heat sources and open flames.
For those seeking a more natural approach, denatured alcohol offers a potent alternative. Denatured alcohol is ethanol mixed with additives to make it unfit for consumption, often reaching concentrations of 95% or higher. Its high alcohol content makes it highly effective against mold spores, even on semi-porous surfaces like sealed wood. However, its strength comes with risks—it’s highly flammable and can damage certain plastics or painted surfaces. Apply it sparingly with a cloth, allow it to sit for 5–10 minutes, then wipe away. Always test on a small area first to avoid discoloration or damage.
Comparing these alcohols, isopropyl is the most versatile for general household use, ethanol is ideal for food-safe areas, and denatured alcohol is best reserved for heavy-duty applications. Each has its strengths and limitations, but all require proper handling to ensure safety and effectiveness. Regardless of the type chosen, consistency is key—repeated applications may be necessary for persistent mold issues. Pairing alcohol treatment with moisture control and ventilation improvements will yield the best long-term results in mold prevention.
Understanding Isolated Spore Syringes: A Beginner's Guide to Mushroom Cultivation
You may want to see also
Explore related products

Alcohol vs. bleach for mold
Alcohol and bleach are both household staples often turned to for cleaning and disinfecting, but their effectiveness against mold spores varies significantly. Alcohol, typically isopropyl alcohol at concentrations of 70% or higher, can kill mold on non-porous surfaces by breaking down the cell walls of the mold spores. However, it evaporates quickly, which limits its contact time with the mold, potentially reducing its efficacy. Bleach, on the other hand, is a powerful oxidizing agent that not only kills mold on contact but also leaves behind residual chlorine compounds that continue to inhibit mold growth. For porous surfaces like wood or drywall, neither may fully penetrate to eliminate deeply embedded spores, but bleach is generally more effective for surface-level mold removal.
When using alcohol to combat mold, apply it undiluted to the affected area and allow it to sit for at least 10 minutes before wiping clean. This ensures sufficient contact time to disrupt the mold’s cellular structure. Bleach, however, should be mixed with water at a ratio of 1 cup of bleach per gallon of water for mold remediation. While bleach is potent, it comes with caveats: it can discolor surfaces, release harmful fumes when mixed with ammonia, and corrode certain materials like metal. Alcohol is a safer alternative for sensitive surfaces like painted walls or fabrics, though it may not be as effective for large-scale mold infestations.
From a practical standpoint, the choice between alcohol and bleach depends on the context. For small, contained mold growth on non-porous surfaces like glass or tile, alcohol is a quick, non-toxic solution. Bleach is better suited for larger areas or stubborn mold on non-porous surfaces, but it requires proper ventilation and protective gear due to its harsh nature. Neither is a foolproof solution for porous materials, where professional remediation may be necessary to address deep-seated mold.
A comparative analysis reveals that while alcohol is gentler and safer for everyday use, bleach offers more immediate and lasting results against mold. Alcohol’s volatility limits its effectiveness, whereas bleach’s residual action provides ongoing protection. However, bleach’s environmental and health risks—such as skin irritation and respiratory issues—make it less ideal for frequent use. For households with children or pets, alcohol may be the preferred choice despite its limitations, as it poses fewer health risks when used correctly.
In conclusion, the decision to use alcohol or bleach for mold remediation hinges on the specific situation and surface type. Alcohol is a versatile, mild option for minor mold issues, while bleach is the heavy-hitter for more severe cases. Always prioritize safety by wearing gloves and ensuring proper ventilation, regardless of the chosen method. For extensive mold problems, consulting a professional is advisable, as DIY solutions may only address surface-level symptoms.
Mastering Spore Print Storage: Essential Tips for Long-Term Preservation
You may want to see also

Long-term effects on surfaces
Alcohol's effectiveness against mold spores is often overstated, especially when considering long-term effects on surfaces. While isopropyl alcohol (rubbing alcohol) can kill mold spores on contact, its efficacy diminishes rapidly once it evaporates. This leaves surfaces vulnerable to recontamination, particularly in humid environments where mold thrives. For instance, wiping a bathroom tile with 70% isopropyl alcohol may sterilize it momentarily, but without addressing underlying moisture issues, mold can regrow within days. This highlights a critical limitation: alcohol is a temporary solution, not a preventive measure.
To maximize alcohol’s impact on surfaces, consider its concentration and application method. A minimum of 70% isopropyl alcohol is necessary to denature mold proteins effectively, but even at this strength, it does not penetrate porous materials like wood or drywall. For non-porous surfaces like glass or metal, apply alcohol undiluted and allow it to sit for at least 10 minutes before wiping dry. However, repeated use of alcohol on painted or varnished surfaces can cause discoloration or degradation, making it unsuitable for long-term maintenance. Always test a small area first to avoid damage.
Comparatively, alcohol’s long-term effects pale against those of mold-specific treatments like vinegar or hydrogen peroxide. While alcohol evaporates quickly, leaving no residue, vinegar’s acetic acid continues to inhibit mold growth even after drying. Hydrogen peroxide, at a 3% concentration, not only kills spores but also breaks down their cell walls, offering residual protection. These alternatives are particularly effective on surfaces prone to recurring mold, such as shower grout or basement walls. Alcohol, by contrast, is best reserved for spot treatments or as a quick disinfectant in emergencies.
A persuasive argument against relying solely on alcohol lies in its environmental and health implications. Frequent use of alcohol-based cleaners contributes to indoor air pollution due to its volatile nature, which can irritate respiratory systems, especially in children or individuals with asthma. Additionally, its production and disposal raise sustainability concerns. For long-term mold management, prioritize moisture control—fixing leaks, using dehumidifiers, and ensuring proper ventilation—over chemical interventions. Alcohol may kill mold spores temporarily, but it does nothing to address the root cause of their presence.
Instructively, if you must use alcohol as part of a mold remediation strategy, combine it with physical removal and preventive measures. After cleaning visible mold with alcohol, follow up with a HEPA vacuum to capture airborne spores. Seal porous surfaces with mold-resistant paint or coatings to prevent future infestations. Regularly inspect high-risk areas, such as under sinks or behind appliances, and maintain humidity levels below 50%. While alcohol has its place in surface disinfection, its role in long-term mold control is limited—a fact that underscores the importance of holistic, proactive approaches.
Frequently asked questions
Yes, alcohol, particularly isopropyl alcohol (rubbing alcohol) with a concentration of at least 70%, can effectively kill mold spores on non-porous surfaces.
Alcohol is less effective on porous materials because it cannot penetrate deeply enough to kill all mold spores. It’s better suited for hard, non-porous surfaces.
Alcohol is safe for small-scale mold removal on non-porous surfaces, but it’s not as effective as specialized mold cleaners or bleach for larger infestations. Always ensure proper ventilation when using alcohol.
























